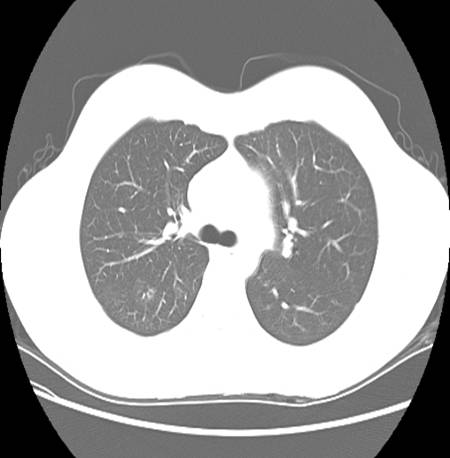
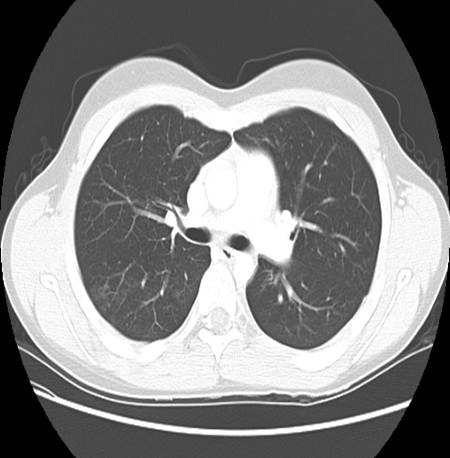
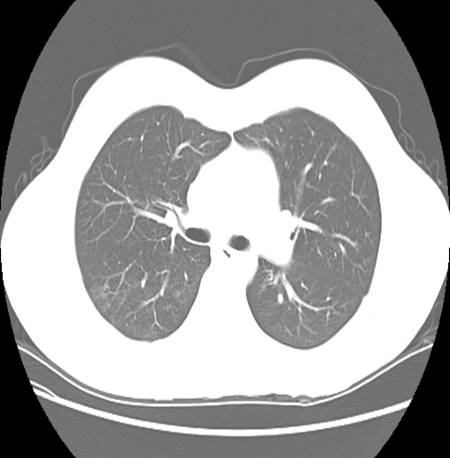

Page 12 / Case
Most likely diagnosis appears to be Wegener's granulomatosis given positive c-ANCA with positive anti-PR3, though there is no apparent renal involvement.
Here is the biopsy report:
Microbiology: few oropharyngeal flora, fungal culture negative, AFB negative
Pathology: acute and chronic inflammation with vasculitis and focal necrosis, no evidence of malignancy
Impression: "distribution, presence of active inflammation with vasculitis, necrosis, and occasional multinucleated giant cells, is consistent with Wegener's granulomatosis"
Nephrology was consulted, and further investigations completed to confirm lack of renal involvement prior to initiation of therapy.
•Creatinine clearance normal, renal ultrasound normal
A CT chest was also ordered to further characterize the pulmonary involvement.
Describe chest CT.
Next page /
ANSWER
Most likely diagnosis appears to be Wegener's granulomatosis given positive c-ANCA with positive anti-PR3, though there is no apparent renal involvement.
Here is the biopsy report:
Microbiology: few oropharyngeal flora, fungal culture negative, AFB negative
Pathology: acute and chronic inflammation with vasculitis and focal necrosis, no evidence of malignancy
Impression: "distribution, presence of active inflammation with vasculitis, necrosis, and occasional multinucleated giant cells, is consistent with Wegener's granulomatosis"
Nephrology was consulted, and further investigations completed to confirm lack of renal involvement prior to initiation of therapy.
•Creatinine clearance normal, renal ultrasound normal
A CT chest was also ordered to further characterize the pulmonary involvement.
![]() Figure 6a |
![]() Figure 6b |
![]() Figure 6bb |
![]() Figure 6c |
![]() Figure 6cc |
Describe chest CT.